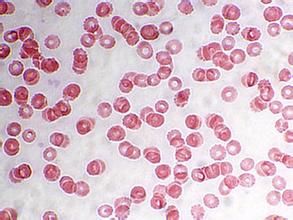
原發性血小板減少症

疾病簡介
 血小板
血小板血小板疾病是由於血小板數量減少(血小板減少症)或功能減退(血小板功能不全)導致止血栓形成不良和出血而引起的.血小板數低於正常範圍14萬~40萬/μl.血小板減少症可能源於血小板產生不足,脾臟對血小板的阻留,血小板破壞或利用增加以及被稀釋。
無論何種原因所致的嚴重血小板減少,都可引起典型的出血:多發性瘀斑,最常見於小腿;或在受輕微外傷的部位出現小的散在性瘀斑;黏膜出血(鼻出血,胃腸道和泌尿生殖道和陰道出血);和手術後大量出血.胃腸道大量出血和中樞神經系統內出血可危及生命.然而血小板減少症不會像繼發於凝血性疾病。
病因特徵
原發性血小板減少症
原發性血小板減少症第二,急性型原發性血小板減少性紫癜也是原發性血小板減少症症狀的一種。這類原發性血小板減少症的症狀常見於兒童,占免疫性血小板減少病歷的90%,
男女發病率相近。起病前1~3周84%病人有呼吸道或其他病毒感染史,因此秋冬季發病最多,起病急促,可有發熱,畏寒,皮膚黏膜紫癜等都是這類原發性血小板減少症的症狀。如果患者頭痛,嘔吐,要警惕顱內出血的可能。病程多為自限性,80%以上可自行緩解,平均病程4~6周。少數可遷延或數年以上轉為慢性。急性型占成人ITP不到10%。
護理
(1) 病情嚴重時,要注意臥床休息,配合治療。
(2) 緩解階段可以適當參加一些鍛鍊,如散步、慢跑、打太極等,以增強體質。
(3) 飲食要有規律,主副食應以高蛋白、維生素為主,如:小麥、玉米、小米、糯米、豆類、瘦肉、蛋類等,多吃新鮮水果和蔬菜如:橘子、紅棗、核桃、紅皮花生、菠菜、白菜。忌食:辛辣油膩及不易消化的食物,煙、酒等刺激性物品。
(4) 儘可能避免使用引起血小板減少的藥物,如利福平,阿司匹林、奎寧、頭孢菌素、洋地黃毒甙等。
(5) 平時要保持心情舒暢,避免精神過度緊張,要保持個人衛生,預防各種感染和感冒,防止外傷。

